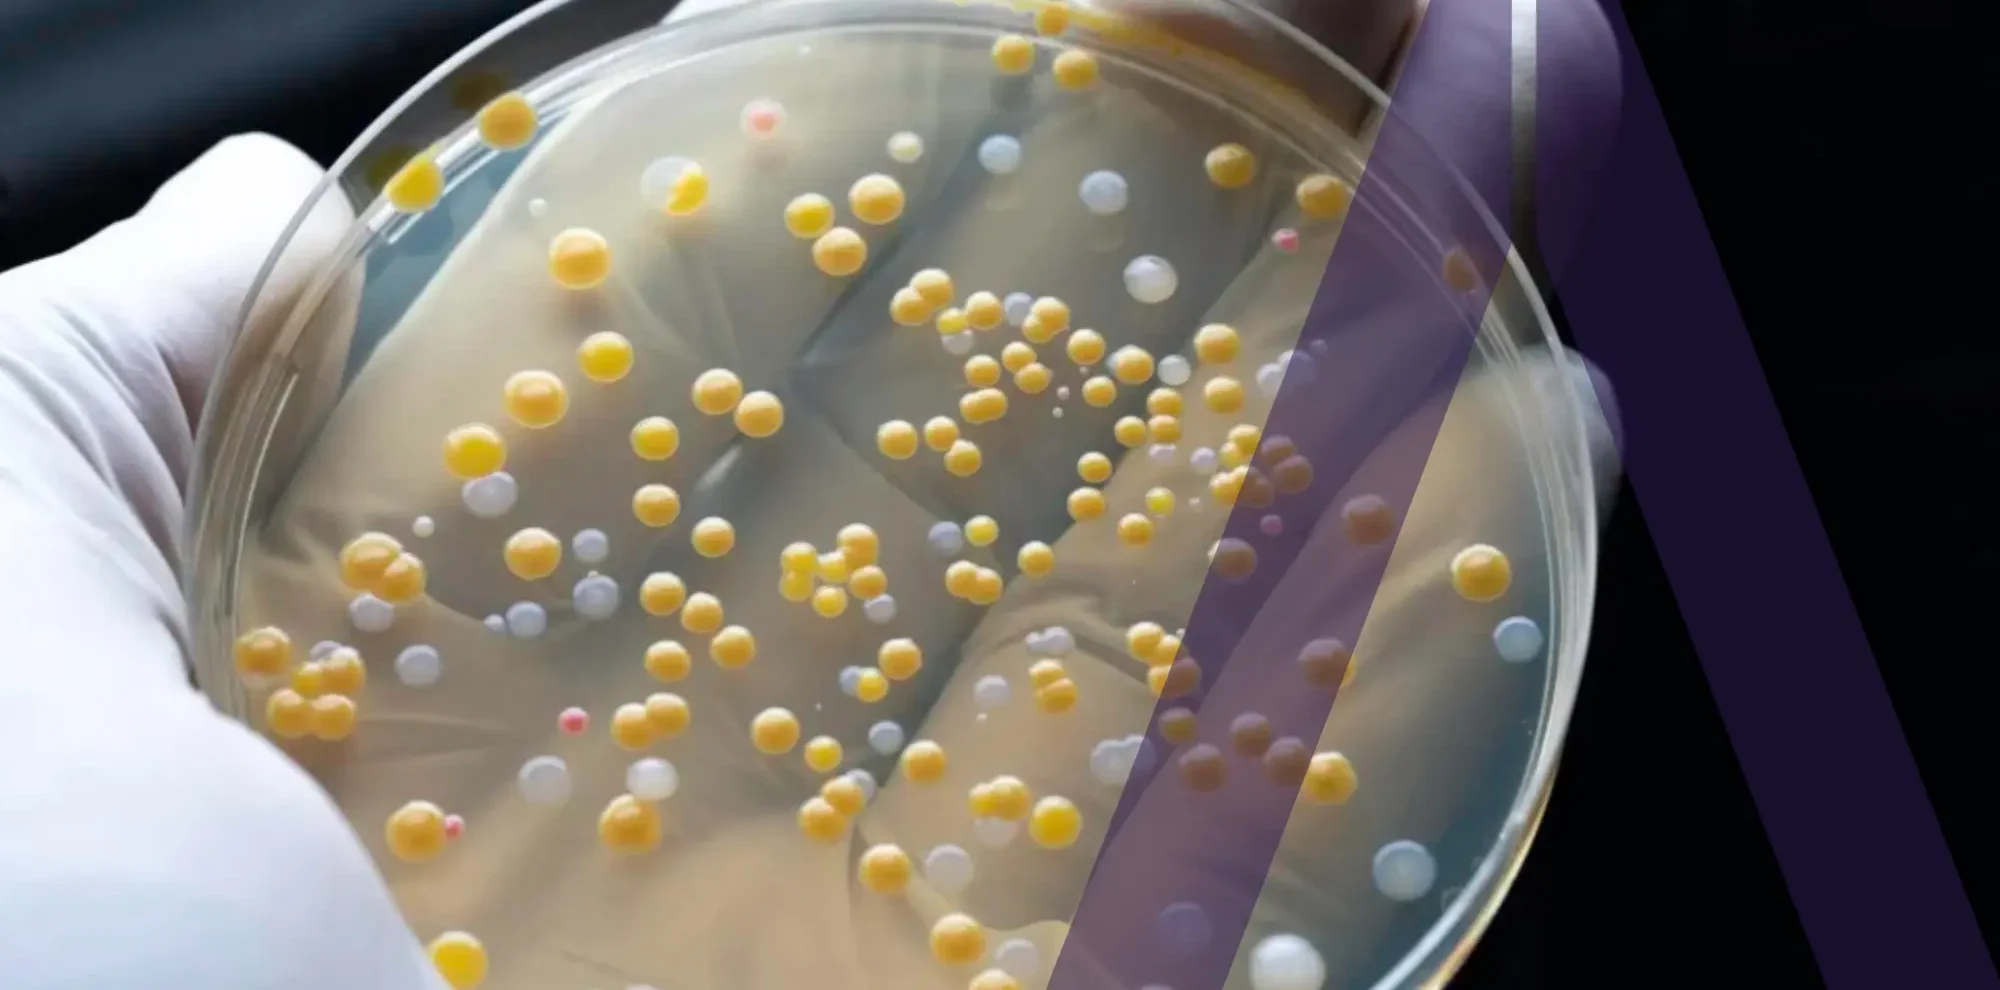

Home / Resources / All Categories
Resources
VIEW BY TOPIC
Allergy
Autoimmune
Biostatistics
Cell and Gene Therapy
Chemistry, Manufacturing, and Controls (CMC)
Clinical Pharmacology
Clinical Trial Operations
Data Management
Dose Optimization
GxP Compliance
Hematology
Immunology and Inflammation
Infectious Disease and Vaccine
Inspection Readiness
Medical Writing
Modeling and Simulation
Neuroscience
Nonclinical/Preclinical
Oncology
Patient Recruitment and Retention
Pediatric
Pharmacokinetics / Pharmacodynamics
Pharmacovigilance and Drug Safety
Project Management
Protocol Development and Study Design
Publishing and Submissions
Rare Disease and Orphan Drugs
Regulatory Affairs
Study Startup and Site Intelligence
Blog
Risk Management: Your Foundation for Better Project Management
View More

Blog
Clinical Highlights from the First Virtual European Society for Medical Oncology Congress
View More
Blog
What is the Difference Between Microbiome and Microbiota?
View More

Blog
The Role of Pre-Clinical Pharmacokinetics in Early Drug Development
View More
Webinar
Next Generation Strategies for Orphan Drug Development
View More

Blog
Improving Informed Consent in Clinical Trials
View More

Blog
Understanding the 3 Types of Clinical Trial Monitoring
View More

Blog
Cellular & Gene Therapy: Implications on Drug Development
View More

Blog
PBPK Modeling & Simulation in Drug Development
View More

Blog
The Importance of Natural History Study to Rare Disease Drug Development
View More

Blog
The Importance of Clinical Trial Transparency for Drug Development
View More

Blog
How to Avoid Clinical Trials Using Modeling & Simulation
View More